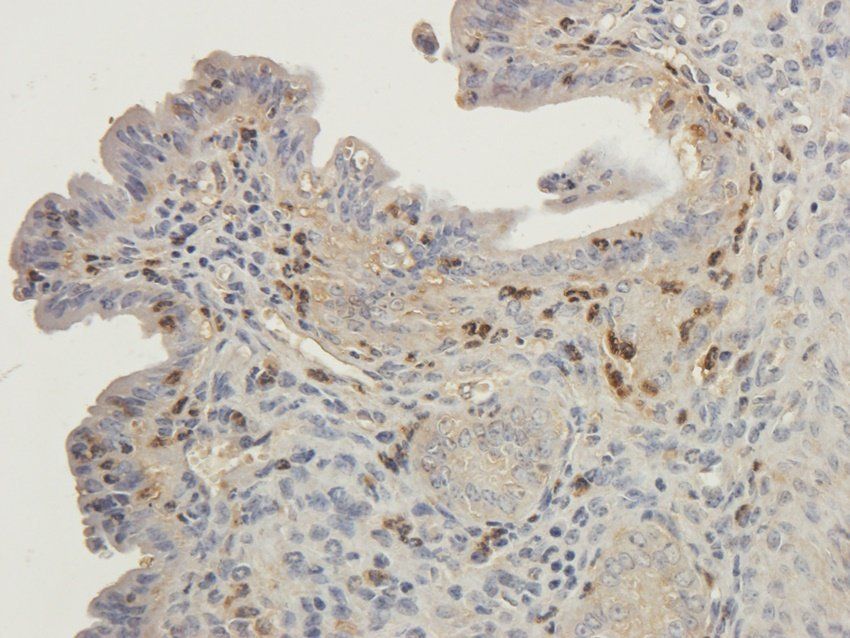
RYR2 Rabbit Polyclonal Antibody

You have no items in your shopping cart.
All Products
- Featured
 PAR2 Rabbit Polyclonal Antibody [orb385619]Featured
PAR2 Rabbit Polyclonal Antibody [orb385619]Featured
ICC, IF, IHC-P, WB
Guinea pig, Human, Mouse, Rat
Rabbit
Polyclonal
Unconjugated
100 μg - CD3E Rabbit Polyclonal Antibody [orb378203]
IHC-P
Human, Mouse, Rat
Rabbit
Polyclonal
Unconjugated
100 μg - ISG15 Rabbit Polyclonal Antibody [orb381901]
IHC-P, WB
Human, Mouse, Rat
Rabbit
Polyclonal
Unconjugated
100 μg - Featured
 RANTES Mouse Monoclonal Antibody [orb382138]Featured
RANTES Mouse Monoclonal Antibody [orb382138]Featured
IHC-P, WB
Human, Rat
Mouse
Monoclonal
Unconjugated
100 μg - NXT2 Rabbit Polyclonal Antibody [orb382149]
ICC, IF, IHC-P, WB
Human, Mouse, Porcine, Rat
Rabbit
Polyclonal
Unconjugated
100 μg - Featured
 MT-ATP8 Rabbit Polyclonal Antibody [orb389303]Featured
MT-ATP8 Rabbit Polyclonal Antibody [orb389303]Featured
IHC-P, WB
Guinea pig, Human, Rat
Rabbit
Polyclonal
Unconjugated
100 μg - RYR2 Rabbit Polyclonal Antibody [orb389351]
ICC, IF, IHC-P
Guinea pig, Mouse
Rabbit
Polyclonal
Unconjugated
100 μg - Featured
 Adiponectin Rabbit Polyclonal Antibody [orb389315]Featured
Adiponectin Rabbit Polyclonal Antibody [orb389315]Featured
ICC, IF, IHC-P, WB
Guinea pig, Mouse, Rat
Rabbit
Polyclonal
Unconjugated
100 μg - HIG2 Rabbit Polyclonal Antibody [orb389656]
ICC, IF, IHC-P, WB
Human, Mouse, Rat
Rabbit
Polyclonal
Unconjugated
200 μg, 100 μg - Featured
 CSEN Rabbit Polyclonal Antibody [orb389319]Featured
CSEN Rabbit Polyclonal Antibody [orb389319]Featured
ICC, IF, IHC-P, WB
Human, Mouse, Rat
Rabbit
Polyclonal
Unconjugated
100 μg